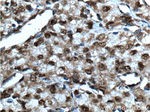
SMARCB1 Antibody in Immunohistochemistry (Paraffin) (IHC (P))

Search
Proteintech
SMARCB1 Polyclonal Antibody
{{$productOrderCtrl.translations['antibody.pdp.commerceCard.promotion.promotions']}}
{{$productOrderCtrl.translations['antibody.pdp.commerceCard.promotion.viewpromo']}}
{{$productOrderCtrl.translations['antibody.pdp.commerceCard.promotion.promocode']}}: {{promo.promoCode}} {{promo.promoTitle}} {{promo.promoDescription}}. {{$productOrderCtrl.translations['antibody.pdp.commerceCard.promotion.learnmore']}}
产品信息
20654-1-AP
种属反应
宿主/亚型
分类
类型
抗原
偶联物
形式
浓度
规格
纯化类型
保存液
内含物
保存条件
运输条件
产品详细信息
The antibody is specific to SMARCB1.
靶标信息
The SWI-SNF complex is involved in the activation of transcription via the remodeling of nucleosome structure in an ATP-dependent manner. Brm (also designated SNF2alpha) and Brg-1 (also designated SNF2beta) are the ATPase subunits of the mammalian SWI-SNF complex. Brm, Brg-1, Ini1 (integrase interactor 1, also designated SNF5), BAF155 (also designated SRG3) and BAF170 are thought to comprise the functional core of the SWI-SNF complex. Addition of Ini1, BAF155 and BAF170 to Brg-1 appears to increase remodeling activity. Other complex subunits are thought to play regulatory roles. hSNF2L and hSNF2H both appear to be homologs of Drosophila ISWI, a Brm related ATPase that is present in chromatin remodeling complexes other than SWI/SNF, including the NURF (nucleosome remodeling factor).
仅用于科研。不用于诊断过程。未经明确授权不得转售。
生物信息学
蛋白别名: BAF47; BRG1-associated factor 47; BRG1-associated factor 47 (BAF47); hSNF5; Ini1; Ini1b; INI1D; INI1E; INI1F; Integrase interactor 1 protein; malignant rhabdoid tumor suppressor; protein phosphatase 1, regulatory subunit 144; SMARCB1; SNF5 homolog; Sucrose nonfermenting yeast homolog like 1; sucrose nonfermenting, yeast, homolog-like 1; SWI/SNF related matrix-associated actin dependent regulator of chromatin, subfamily b, member 1; SWI/SNF related, matrix associated, actin dependent regulator of chromatin, subfamily b, member 1; SWI/SNF-related matrix-associated actin-dependent regulator of chromatin subfamily B member 1; SWI/SNF-related matrix-associated protein; SWI10; Transcription factor TYE4; Transcription regulatory protein SNF5; TYE4; unnamed protein product
基因别名: BAF47; CSS3; hSNFS; INI-1; INI1; MRD15; PPP1R144; RDT; RTPS1; Sfh1p; SMARCB1; SNF5; SNF5L1; Snr1; SWNTS1
UniProt ID: (Human) Q12824
Entrez Gene ID: (Human) 6598